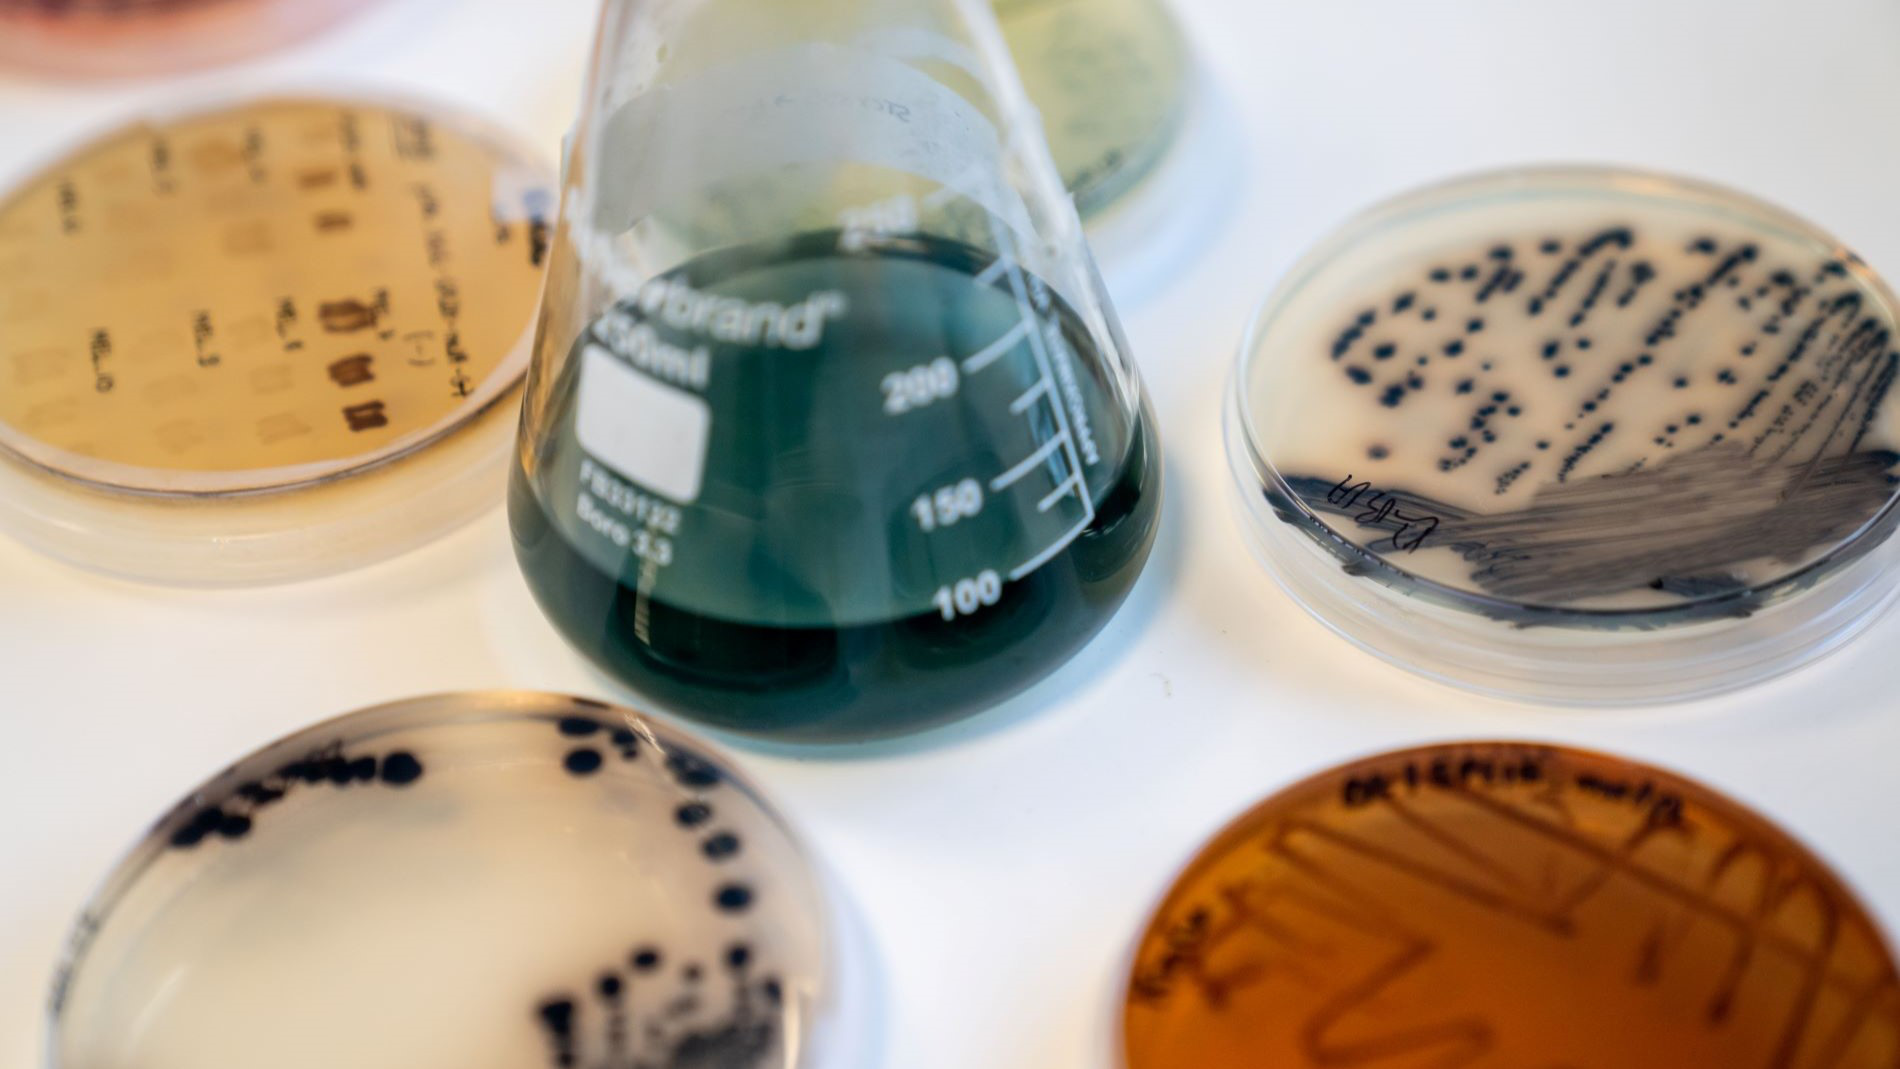

Lesedauer: 4 Minuten
Farben aus der Natur werden seit je her für das textile Färben eingesetzt. Das britische Unternehmen Colorifix geht noch einen Schritt weiter. Sein Prozess ersetzt nicht nur Chemie durch Biologie, sondern nutzt Farben, die von Organismen in der Natur, wie Tieren, Pflanzen oder Mikroben, produziert werden. Das Besondere: Durch das schadstofffreie und ressourcenschonende Verfahren können Färbereien ihre Farben selbst herstellen – und zwar zum Zeitpunkt und in der Menge ihrer Wahl. Das sorgt für Planungssicherheit und Unabhängigkeit von aktuellen Lieferketten.

Andreas Andren, Head of Business Development bei Colorifix, erläutert das Verfahren und dessen besondere Benefits.
Die Ursprünge von Colorifix gehen auf ein Verfahren zurück, das zur Überwachung von Schwermetallverschmutzung entwickelt wurde. Wie kam es zu der Unternehmensidee?
Während ihrer Forschungen mit Biomarkern in Nepal und Bangladesch im Jahr 2013 entdeckten unsere beiden Gründer Jim Ajioka und Orr Yarkoni unerwartet starke Verunreinigungen im Wasser. Diese Verschmutzungen wurden auf Färbeprozesse und Nassverfahren in der Textilindustrie zurückgeführt. Die beiden machten sich daran, zu untersuchen, ob das Problem mit biologischen Mitteln gelöst werden könnte – und das war der Startpunkt für das Unternehmen Colorifix.
Von der Gründung 2013 bis heute ist eine ganz schön lange Zeit.
Nun, es ist so: Die Herstellung einer Farbe mithilfe von Mikroorganismen mag auf den ersten Blick recht einfach erscheinen. Die große Herausforderung besteht jedoch darin, die Qualitätsanforderungen der Industrie zu erfüllen. Textilfarben müssen gleichmäßig, waschbar, schweiß- und lichtbeständig sein usw. Diese Entwicklung hat Zeit gebraucht. Aber wir haben den Code geknackt.
Wie läuft das Verfahren für Ihre Kund*innen ab?
Wir identifizieren eine gewünschte Farbe in der Natur, suchen in verfügbaren Datenbanken nach dem entsprechenden Gen und rekonstruieren die spezifische DNA-Kette. Diese wird dann in einen Chassis-Organismus implantiert, der „lernt“, die Farbe zu reproduzieren. Die Mikroorganismen werden anschließend gefriergetrocknet und in einem kleinen Fläschchen zur Färberei transportiert. Ein Vorteil ist, dass unsere Kunden die benötigte Menge an Farbstoff vor Ort produzieren können. Sie geben einfach das gelieferte Fläschchen in einen unserer Fermenter, und nach 16 bis 20 Stunden vermehrt sich der Mikroorganismus von 1 auf 8 Milliarden. Die entstehende Flüssigkeit bildet das gesamte Färbebad und kann ohne Änderungen in die meisten bestehenden Färbesysteme eingespeist werden.
Der Unterschied zu herkömmlichen Verfahren besteht darin, dass unser Färbeprozess kein zusätzliches Wasser benötigt, weniger Zeit in Anspruch nimmt und bei niedrigeren Temperaturen abläuft, was zu einer erheblichen Einsparung von Wasser, Strom und CO2 führt. Am Ende des Prozesses wird die Färbeflotte kurz auf 120 oder 90 Grad erhitzt, um die Mikroorganismen zu deaktivieren. Der Stoff nimmt bis zu 98 Prozent der Farbe auf. Übrig bleiben die deaktivierten Mikroorganismen, also harmlose Biomasse.

Das heißt, Ihre Kund*innen produzieren ihre Farbe im Prinzip selbst? Das klingt ziemlich revolutionär.
Ja, das ist es, vor allem weil wir den Färbereien die Kontrolle über ihr Produkt geben, was ihnen ein hohes Maß an Unabhängigkeit, Planungssicherheit und Flexibilität verschafft. Wir versenden keine großen Mengen fertiger Farben um die Welt, sondern nur kleine Pakete mit den Fläschchen. Unsere Kunden können diese lagern und die benötigte Menge an Farbstoff selbst herstellen, wann immer sie diese benötigen. Ein weiterer Faktor ist die Transparenz. Große Chemieunternehmen geben nur sehr wenige Informationen über ihren Ressourcenverbrauch oder die von ihnen verwendeten Chemikalien preis. Mit unserem Verfahren können Unternehmen ihre eigene Lieferkette kontrollieren.
Das hört sich gut an, aber die Färbereien müssen zunächst in die Fermenter investieren, oder?
Ja, es gibt eine kleine Anfangsinvestition. Aber wir helfen den Unternehmen in vielerlei Hinsicht. Unsere Systeme sind sehr kosteneffizient konzipiert und etwa dreimal günstiger als herkömmliche Fermenter, wie sie beispielsweise in der Pharmaindustrie eingesetzt werden. Dazu arbeiten wir an Finanzierungslösungen und haben beispielsweise eine Kofinanzierung eingerichtet. Darüber hinaus gibt es Fördermittel für solche Projekte. Langfristig zahlt sich das also aus.

Wie ist die Resonanz im Markt?
Man merkt, dass der Markt jetzt bereit ist. Wir sind ja seit einigen Jahren kommerziell aktiv und haben bislang mit ausgewählten Partnern recht erfolgreich an Proof-of-Concepts gearbeitet. Jetzt treten wir in die Skalierungsphase ein. In Südamerika, Europa und Südasien sind wir bereits gut vertreten und bauen unsere Kapazitäten an mehreren Standorten aus. Es geht also jetzt richtig los.
Fazit
Die Transformation in der Textilindustrie ist in vollem Gange und immer mehr zeigt sich, dass sich ein Umsteigen auf nachhaltige Textilfarben zahlreiche Benefits bieten kann, die sich auf verschiedenen Ebenen auszahlen können. Von der Ersparnis von Energie, Wasser und Zeit über die Kontrolle übers eigene Produkt bis dahin, dass die neuen mutig und transparent agierenden Player den Wettbewerb beflügeln: Für textilfärbende und textilverarbeitende Unternehmen bedeutet diese spannende Entwicklung auf jeden Fall, dass ihnen immer mehr zeitgemäße Alternativen zur Verfügung stehen, die sich schnell zum relevanten Wirtschaftsfaktor werden können.
Titelbild: Colorifix rekonstruiert die spezifische DNA-Kette. © Colorifix
Serie: So kann's gehen
Über die Serie
Die Herausforderungen für Unternehmen der Textilindustrie sind facettenreich und, einfach ausgedrückt, nicht ohne. Sie reichen von steigenden Kosten für Rohstoffe und Energie über Fachkräftemangel und Lieferketten bis hin zu den Megatrends Nachhaltigkeit und Digitalisierung.
Innovative Unternehmen nutzen ihre Chancen und generieren aus der Herausforderung ihr Businessmodell. Allein gelingt das allerdings selten. Netzwerke von Wirtschaft und Forschung sind gefragt.
In der Serie „So kann’s gehen“ stellen wir Unternehmen, Start-ups und Marktführer vor, die sich einem Problem nicht nur annehmen, sondern daraus ein zukunftsfähiges Business entwickelt haben.
Weitere Artikel der Serie:
Biologische Farben als Wirtschaftsfaktor (Teil 1)
Circular Economy ist keine Modeerscheinung
Einer für alle. Wie Kreislaufwirtschaft funktionieren kann. (Teil 1)
Einer für alle. Wie Kreislaufwirtschaft funktionieren kann. (Teil 2)
Einer für alle. Wie Kreislaufwirtschaft funktionieren kann. (Teil 3)